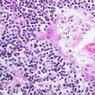
A45, Thymus (Infant), 40x (H&E)
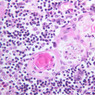
lym

You are here: Medical Histology>Main Web>AtlasContents>LymphaticSystemAtlas07 (20 Jun 2015, LorenEvey)Edit Attach
Chapter Seven: Lymphatic System
Introduction
Lymphatic tissue is found in five principal locations: 1) the mucosal lamina propria (i.e., upper respiratory tract, alimentary canal, urinary system); 2) lymph nodes; 3) spleen; 4) thymus; and 5) bone marrow. In general, lymphoid tissue consists of stroma and parenchyma. The stroma consists of a network of reticular cells that support the parenchymal cells and the walls of the sinuses. The parenchymal cells include lymphocytes (mature as well as immature cells), plasma cells, and macrophages. Prior to learning the microarchitecture of Lymphatic Tissue, use the table below to review some of the gross anatomy of the lymphatic system:| Structure | Image |
|---|---|
| Lymph Nodes of the Head and Neck | |
| Gastric Lymph Nodes and Spleen | |
| The Spleen | |
| The Thoracic Duct | |
| The Thymus | |
Lymph Vessels
Delicate lymphatic channels consisting of capillaries and larger vessels are spread throughout the body. Periodically along these channels are small collections or complex aggregations of lymphocytes associated with delicate meshworks of reticular tissue. Approximately 50% of the plasma volume is lost each day to the tissues so a major function of the lymphatic channels is to collect fluid from tissue spaces and return it to the blood; but in transit, the plasma-like fluid is filtered through lymphoid tissue. Lymphatic vessels and tissue constitute a very widespread and extremely important filtering system between the body tissues and the bloodstream, and they prevent the spread of infectious agents by the vascular system. Lymphatic capillaries and vessels also transport proteins and other substances that leak from blood capillaries back to the blood via the thoracic and right lymphatic ducts, and in the intestines they are a principal pathway for carrying fats from the absorptive cells of intestinal villi to the bloodstream. Lymph capillaries are readily seen, but often go unnoticed in sections of tissue where they may be mistaken for fixation shrinkage artifacts. Examine intestinalthe villi in section B-12 and find the blind-ending capilliform vessel that lies in the axis of the villus (B-12, H&E [10x-labeled, 20x, 40x-labeled] [10x, 20x-labeled, 40x] [10x, 20x, 40x-labeled]; B-15, H&E [2.5x, 10x, 20x, 40x] [2.5x, 10x. 20x, 40x]). This is a lymph capillary known as a lacteal (because of its milky appearance after a fatty meal). Note its thin endothelial wall and its irregular lumen, common features of lymphatic vessels. Lacteals, in their passage to deeper-lying lymphatic vessels, usually pass through diffuse collections of lymphoid tissue. Lymphatic vessels larger than capillaries are similar in structure to comparable-sized veins, but have thinner walls. Thus, try to find vessels in the intestinal submucosa that seem to be venules, but have no cellular content. These are likely lymphatic vessels. Periodically along the lymphatics (and the venules also) valves occur, which are infoldings of the intimal layer of the vascular wall. These structures prevent backflow of lymph (or blood) ensuring a uni-directional flow. Lymphatic vessels are difficult to find and valves are rarely observed (i.e., don't spend too much time trying to identify these structures).Lymph Vessel Image Gallery
Lymph Vessel Table of Identifications
| Row | Structure | Abbreviation | Optimal Stain | Representative Section | Note |
|---|---|---|---|---|---|
| 1 | Endothelial Cell | EC | H&E | |
|
| 2 | Lacteal | L | H&E | |
|
| 3 | Lamina Propria | LP | H&E | |
|
| 4 | Villus | V | H&E | |
|
| 5 | Intestinal Gland (Crypt) | Gl | H&E | |
|
| 6 | Lymphatic Vessel | LV | H&E | |
|
| 7 | Lymphatic Tissue (Lamina Propria) | LP/LT | H&E | |
Top of page
Diffuse Lymphatic Tissue and Nodules
The visceral walls have concentrations of lymphoid tissues that comprise the body's filters against foreign organisms that attempt to enter by way of the alimentary, urinary, or respiratory tracts. The lamina propria is a layer of connective tissue underlying the epithelium of mucous membranes; lymphatic tissue is often found in the lamina propria. This lymphatic tissue can assume three forms; 1) diffuse lymphatic tissue, 2) solitary lymphatic nodules, and 3) aggregated lymphatic nodules. The simplest arrangement of lymphoid tissue occurs as diffuse patches of lymphocytes scattered in the lamina propria of the walls of visceral organs. When a patch becomes activated by antigens or foreign organisms, it takes on the appearance similar to a nodule in the cortex of a lymph node (see below). These nodules are not encapsulated and simply occur in the visceral wall as an accumulation of lymphocytes, macrophages, and plasma cells embedded in reticular tissue. Eosinophilic leukocytes are frequently seen. Examine sections B-12 (jejunum, H&E [2.5x, 10x-labeled, 20x, 40x]); B-16, ileum, H&E [2.5x-labeled, 10x, 20x]; B-18, ileum, H&E [2.5x, 10x-labeled, 20x, 40x]; B-20, appendix, H&E [2.5x, 10x-labeled, 20x, 40x-labeled]) and find examples of diffuse lymphatic tissue. Solitary nodules of lymphoid tissue as well as diffuse lymphoid tissue can be found almost anywhere along the gastrointestinal system (this is sometimes called GALT, gut associated lymphoid tissue). The most noted areas with aggregated nodules are found in ileum—Peyer’s Patches (slide B-18, H&E [2.5x-labeled, 10x-labeled, 20x, 40x] [2.5x, 10x, 20x, 40x]), and appendix (slide B-20, H&E [2.5x, 10x, 20x, 40x] [2.5x, 10x,20x, 40x] [2.5x-labeled, 10x, 20x-labeled, 40x]). Peyer's Patch consists of aggregated nodules of lymphoid tissue. Compare the appearance of Peyer's patches to the lymphoid tissue in the appendix. In the appendix, the lymphoid tissue of the appendix appears as a continuous ring of lymphatic tissue in the lamina propria. What features differentiate the appendix from the Ileum? In lymphatic nodules and nodes the term primary nodule refers to a nodule of homogeneously, tightly packed small lymphocytes. When lymphatic nodules have germinal centers they are called secondary nodules. A germinal center contains lighter staining, "B" lymphocyte precursors. Mitotic figures should be easily spotted in the core of the nodule. Compare these cells with the mass of small more differentiated lymphocytes that surround the germinal center. Some of these lymphocytes are cytokine producing T-Helper cells that are stimulating the proliferation of the lymphoblasts.Diffuse Lymphatic Tissue and Nodule Image Gallery
Diffuse Lymphatic Tissue and Nodule Table of Identifications
| Row | Structure | Abbreviation | Optimal Stain | Representative Section | Note |
|---|---|---|---|---|---|
| 1 | Diffuse Lymphatic Tissue | (none) | H&E | |
|
| 2 | Peyer's Patches (Aggregated Lymphoid Nodules) | LN | H&E | |
|
| 3 | Submucosa | SubM | H&E | |
|
| 4 | Lamina Propria | LP | H&E | |
|
| 5 | Intestinal Glands | IG | H&E | |
|
| 6 | Secondary Lymphoid Nodule | (none) | H&E | |
|
| 7 | Germinal Center | GC | H&E | |
|
| 8 | Corona | C | H&E | |
|
| 9 | B Lymphocyte Precursor | Bp | H&E | |
|
| 10 | Mitotic Figures | MF | H&E | |
|
| 11 | Differentiated Lymphocyte | DL | H&E | |
|
| 12 | Primary Nodule | (none) | H&E | |
|
| 13 | Secondary Nodule | (none) | H&E | |
Top of page
Partially Encapsulated Lymphoid Tissue
The first site of defense against foreign agents entering the body through the mouth and nose is the ring of tonsils around the posterior oro- and nasopharynx. The tonsil is a mass of confluent lymphoid nodules beneath the pharyngeal epithelium. Examine slide A-41 (retic-H&E [2.5x, 2.5x-labeled] [2.5x, 10x-labeled, 20x, 40x] [2.5xlabeled, 10x, 20x, 40x]). Tonsillar tissue is not separable into cortical and medullary regions, and it does not contain lymphatic vessels. The lymphoid masses, as in the nodules of the stomach and intestine, lie just beneath the epithelium where they can intercept bacteria and viruses that either invade or are phagocytosed by the overlying epithelium. The tonsil is invested by a fibrous tissue and is incompletely subdivided by inward-projecting trabeculae. Blood vessels in the tonsillar substance leave randomly through the fibrous tissue. What features differentiate the tonsil from the ileum?Partially Encapsulated Lymphoid Tissue Image Gallery
Partially Encapsulated Lymphoid Tissue Table of Identifications
| Row | Structure | Abbreviation | Optimal Stain | Representative Section | Note |
|---|---|---|---|---|---|
| 1 | Epithelium | Ep | H&E | |
|
| 2 | Tonsillar Crypt | TC | H&E | |
|
| 3 | Lymphatic Nodule | LN | H&E | |
|
| 4 | Stratified Squamous Epithelium | SSE | H&E | |
|
| 5 | Trabecula | (none) | H&E | |
Top of page
Encapsulated Lymphoid Tissue
The most specialized lymphoid tissues are the encapsulated organs; 1) lymph nodes (which filter extracellular fluids); 2) the spleen (which filters blood); and 3) the thymus (which produces T lymphocytes).Lymph Nodes
When foreign substances or antigens get into body tissues, such materials are usually taken into the lymph and transported to aggregations of lymphoid tissue called lymph nodes (slide A-32, H&E [2.5x-labeled, 10x, 20x, 40x] [2.5x-labeled, 10x, 20x] [2.5x, 10x, 20x-labeled, 40x]; A-33, H&E [2.5x, 10x, 20x, 40x]; A-34, retic [2.5x, 10x, 20x, 40x-labeled]; A-35, H&E [2.5x, 10x, 20x, 40x]), which are composed of lymph nodules invested by a distinct connective tissue capsule. The node is visibly separable into a cortex, where the densely stained nodules are concentrated, and a light staining medulla (A-32 [2.5x, 10x-labeled, 20x, 40x]). Strands, or trabeculae, of connective tissue separate the node into cortical compartments and join centrally in the node to emerge at the indented side known as the hilus. Small arteries and veins enter and leave the node at the hilus, being distributed in the node through the trabeculae. Capillary branches from the arteries are spread throughout the lymphoid node. Multiple afferent lymphatic vessels penetrate the capsule of the node, emptying into a subcapsular sinus which is a relatively cell-free zone (A-32 [2.5x, 10x, 20x, 40x-labeled]). Unidirectional flow of lymph from the afferent lymphatics into the sinus is assured by the valves in the vessels. From the subcapsular sinuses, lymph percolates through the relatively unobstructed cortical sinuses to the medulla. During this flow the lymph is filtered by phagocytes and foreign antigens are presented to lymphocytes by dendritic cells, the resident antigenpresenting cells. Nodules are formed as needed and subsequently disappear. Lymph finally reaches the medullary sinuses bounded by wide cords of tissue and passes out of the node at the hilus through the sole efferent lymphatic vessel. The lymphoid tissue of a node is thus divisible into the nodules in the cortex and looser cords in the medulla. In the cortex, carefully examine a secondary nodule, composed of a dense outer rim of cells and a more loosely organized core (germinal center). In between the nodules find larger cells with pale, oval nuclei. These are reticular cells and will be most easily identified in the reticular-stained preparation (A-34 [2.5x, 10x, 20x, 40x] [10x, 20x, 40x]). The reticular fibers cells make up the CT scaffolding of the lymph node. Note that there are fewer reticular fibers in the germinal centers. Medium-sized cells with pale nuclei, particularly cells with a prominent nucleolus, may be progenitor cells of new lymphocytes. Macrophages present in the nodule are hard to distinguish unless they contain phagocytosed material. In the medulla, cell types in the cords are easier to distinguish because cytoplasmic size and extent can be seen. For example, the differences between large lymphocytes and reticular cells can be seen. Several types of granular leukocytes are frequently found in the cords in addition to the expected population of lymphocytes and plasma cells. Another important structure to identify is the high-endothelial or post-capillary venule (A-32, [2.5x, 10x, 20x, 40x-labeled] [10x, 20x, 40x] [2.5x, 10x, 20x, 40x-labeled]; A-33 [2.5x, 10x, 20x, 40x-labeled]). Lymphocytes from the blood enter and leave the lymph nodes through post-capillary venules. These structures are characterized by high columnar or cuboidal endothelial cells. They are most often located in the paracortical zone, which is at the junction of the cortex and medulla. Locate a postcapillary venule on slide A-32. What advantage is gained by having lymphocytes entering and leaving the lymph node?Lymph Node Image Gallery
Lymph Node Table of Identifications
| Row | Structure | Abbreviation | Optimal Stain | Representative Section | Note |
|---|---|---|---|---|---|
| 1 | Capsule | C | H&E | |
|
| 2 | Superficial Cortex | SC | H&E | |
|
| 3 | Deep Cortex | DC | H&E | |
|
| 4 | Medulla | M | H&E | |
|
| 5 | Hilus | (none) | H&E | |
|
| 6 | Subcapsular (Cortical) Sinus | CS | H&E | |
|
| 7 | Lymph Node | LN | H&E | |
|
| 8 | Trabecular Sinus | TS | Reticulin | |
|
| 9 | Capillary | C | H&E | |
|
| 10 | Medullary Sinus | MS | H&S | |
|
| 11 | Medullary Cords (of Lymphocytes) | MC | H&E | |
|
| 12 | Reticular Cell | RC | H&E | |
|
| 13 | Macrophage | M | H&E | |
|
| 14 | Lymphocyte | L | H&E | |
|
| 15 | High Endothelial (Post-capillary) Venule | (asterisk), (arrows) | H&E | |
Top of page
Spleen
The spleen is structurally arranged to filter out foreign agents, and to destroy worn-out red blood cells. To accomplish this, the blood leaves the blood vessels and passes through a meshwork of reticular tissue where phagocytic cells can pick out bacteria and antigenic materials as well as worn-out red blood cells. Sections through the spleen (slides A-36, aniline blue [2.5x, 10x, 20x-labeled, 40x] [2.5x, 10x-labeled, 20x-labeled, 40x]; A-37, retic [2.5x, 10x, 20x-labeled, 40x]; A- 37, H&E [2.5x-labeled, 10x, 20x, 40x]; A-38, H&E [10x, 20x, 40x]; A-39, H&E [2.5x, 10x, 20x, 40x]) show a thick investing capsule composed of collagenous tissue and smooth muscle, typically covered with mesothelium. In slide A-36 muscle and collagen are brightly stained. The capsule and mesothelium completely surround the organ and the fibrous portion enters the splenic substance at the hilus around the splenic arteries and veins forming trabeculae of fibromuscular tissue within the splenic substance. This fibromuscular tissue enables the spleen to expel blood by contracting. Identify trabeculae as fibrous partitions in the section and look for blood vessels within them. Where the trabecular arteries pass into the splenic pulp, they become invested by a sleeve of lymphoid tissue. This lymphatic tissue collectively forms the white pulp of the spleen (A-36 [2.5x, 10x, 20x, 40x]). It also is referred to as the periarterial lymphatic sheath or PALS. On an H&E stained section (A-38 [2.5x, 10x, 20x, 40x] [2.5x, 10x, 20x, 40x]) the white pulp will appear as basophilic clumps of lymphoid cells. The arteries of the white pulp are called central arteries, although they may be displaced to one side of the lymphoid sleeve by the presence of a nodule. The majority of cells forming the PALS are T lymphocytes. In places the covering of lymphatic tissue is enlarged due to the presence of lymphoid nodules (splenic or Malphighian corpuscles) which are comprised predominantly of B lymphocytes. The remainder of the cellular mass in the spleen is red pulp (A-38 [10x, 20x, 40x]), made up of red and white cells of the blood enmeshed in the reticular tissue of splenic cords and present in the splenic sinuses. After passing through the PALS, the trabecular arteries branch to form smaller arterial vessels known as penicillar arterioles which narrow, forming arterial capillaries that empty into the cords of the red pulp (open circulation) or into the venous sinuses (closed circulation). In the splenic sinuses the cells of the blood are exposed to red pulp macrophages. The splenic sinuses eventually become confluent to form veins that enter the trabeculae and gradually merge meeting in the hilus to form splenic veins. Examine the composition of the red pulp tissue. The three dimensional structure of the red pulp is analogous to Swiss cheese with the holes being the venous sinuses and the cheese being the parenchyma (i.e. splenic cords). On slide A-36 which is stained with Mallory's aniline blue locate examples of the splenic sinuses ([2.5x, 10x, 20x, 40x-labeled] [10x, 20x, 40x]). The walls of the splenic sinuses consist of adjoining specialized endothelial cells whose nuclei in many cases stand out from the wall in a bead-like fashion. The basement membrane of the epithelial cells stains blue revealing the sinuses quite nicely. Usually the sinus lumen is filled with red cells and leukocytes. The skeletal framework of the cords is provided by a network of reticular fibers. As above, the reticular cells are best seen using a reticular fiber stain (slide A-37 [2.5x, 10x, 20x, 40x-labeled]). Look for the large pale nuclei of reticular cells that have darkly stained reticular fibers. Fibers run irregularly in the cords, but clearly outline the sinuses around which they are wrapped. Notice on this same slide that there is much less reticular tissue in the white pulp than the red. The splenic cords occur around the sinuses and are distinguished by the presence of disintegrating red blood cells undergoing phagocytosis. Here's a little histopathology: Observe slide A-40 (H&E [2.5x, 10x, 20x, 40x]). In this slide the corpses of red blood cells appear brown and can be seen littered throughout. These residual RBCs are referred to as hemosiderin. Slide A-39 (H&E [2.5x, 10x, 20x, 40x]) was prepared from a patient undergoing chemotherapy. How does the white pulp in this slide differ from the normal spleen, slide A-38?Spleen Image Gallery
Spleen Table of Identifications
| Row | Structure | Abbreviation | Optimal Stain | Representative Section | Note |
|---|---|---|---|---|---|
| 1 | Hilus | (none) | Aniline Blue | |
|
| 2 | Mesothelium | (none) | Aniline Blue | |
|
| 3 | Artery | (none) | Aniline Blue | |
|
| 4 | Trabecula | T | Aniline Blue, Reticulin | |
|
| 5 | Venous Sinus | VS | Aniline Blue, Reticulin | |
|
| 6 | White Pulp | WP | Aniline Blue | |
|
| 7 | Red Pulp | RP | Aniline Blue | |
|
| 8 | Central Artery | CA | Aniline Blue | |
|
| 9 | Vein | (none) | Aniline Blue | |
|
| 10 | Artery | (none) | Aniline Blue | |
|
| 11 | Trabecular Vein | TV | Reticulin | |
|
| 12 | Capsule | (none) | H&E | |
|
| 13 | Endothelial Cell Nucleus | N | Aniline Blue | |
|
| 14 | Basement Membrane | BM | Aniline Blue | |
|
| 15 | Reticular Cells | RC | Reticulin | |
Top of page
Thymus
Another encapsulated lymphoid organ is the thymus. In the developing animal, this tissue contains the most important concentration of lymphocytes in the body. If the thymus is removed, lymphoid nodular tissue elsewhere does not develop properly and the ability of the animal to develop immunological competence is impaired. In a newborn or young animal, therefore, the thymus is a large lymphoid structure. After maturity the thymus undergoes involution, although some of the structural features persist and will be found embedded in fatty tissue. Examine slides A-43 through A-46 (A-43, H&E [2.5x, 10x, 20x]; A-44, H&E [10x, 20x, 40x]; A-46, H&E [2.5x-labeled, 10x, 20x-labeled, 40x]). Slides A-44 and [[http://www.medicalhistology.us/wiki/bin/viewfile/Main/ThymusImages?rev=1;filename=a45_hassall_corpuscle_medulla_infant_thymus_2x.jpg][A- 45]] are from infants and slide A-46 is from a young adolescent. Compare slide A-43 (adult thymus) to slide A-44 (infant thymus). First hold the slides up to the light and observe by eye that there is an increase in the amount of CT (and fat) that infiltrates the tissue with age. Now observe the differences in the appearance of the tissue at the microscopic level. Like the lymph node and spleen, the thymus is encapsulated, and the capsular connective tissue penetrates into the lymphoid tissue dividing it into compartments. But only the thymus appears lobulated. Each lobule is divided into a darker staining peripheral cortex and a lighter staining medulla. Diagnostic of the thymus are Hassall's corpuscles (A-45 [2.5x, 10x, 20x, 40x-labeled]). These are concentrically layered, eosinophilic structures found in the medulla. Examine a section of young thymus (slides A-44, A-45). Note that it is surrounded by a thin CT capsule. Trabeculae from the capsule pass into the organ to divide the thymus incompletely into lobes (separated by thick trabeculae) and lobules (separated by thinner trabeculae). Notice that the lobules and lobes join centrally, making the parenchyma of the organ continuous throughout. Each lobule shows an outer, cortical region, densely packed with cells that are mostly lymphocytes, and a core or medullary region containing fewer cells. Lymphoid nodules with their germinal centers are absent from the thymus because it has no afferent lymphatics, i.e. this organ does not filter lymph. Examine the cortex and find large and small lymphocytes (A-44, H&E [2.5x, 10x, 20x, 40x] [2.5x, 10x, 20x, 40x]; A-45, H&E [10x, 20x, 40x] [2.5x, 10x, 20x, 40x] [2.5x, 10x, 20x, 40x]). Look for mitotic figures in the thymic cortex; these are lymphoblasts. Also try to discern large cells with acidophilic cytoplasm and large nuclei interspersed among the lymphocytes. These are the epithelioreticular cells. Now look at the medullary region where lymphocytes are sparser (A-44, H&E [10x, 20x, 40x]; A-45, H&E [2.5x, 10x, 20x, 40x-labeled] [10x, 20x, 40x]). Epithelioreticular cells are more readily apparent. Unlike the reticular cells in other lymphatic organs which are of mesenchymal descent, these reticular cells arise from epithelium of the pharyngeal pouches. Like other epithelial cells, thymic reticular cells are joined by desmosomes. In the thymus, the epithelioreticular cells form a cellular reticulum that supports the thymocytes. Scattered randomly in the medullary tissue are acidophilic structures whose cells are concentrically arranged around an amorphous core. These are the thymic or Hassall's corpuscles. Hassall's corpuscles vary in size and appearance and are comprised of degenerated reticular cells that contain keratohyalin granules and keratin. No known function has been assigned to them.Thymus Image Gallery
Thymus Table of Identifications
| Row | Structure | Abbreviation | Optimal Stain | Representative Section | Note |
|---|---|---|---|---|---|
| 1 | Trabeculae | T | H&E | |
|
| 2 | Medulla | M | H&E | |
|
| 3 | Cortex | C | H&E | |
|
| 4 | Adipose Tissue | AT | H&E | |
|
| 5 | Capsule | (none) | H&E | |
|
| 6 | Blood Vessel | BV | H&E | |
|
| 7 | Hassall's Corpuscle | H | H&E | |
|
| 8 | Epithelioreticular Cells | E | H&E | |
|
| 9 | Lymphoblasts (Mitotic Figures) | L | H&E | |
Top of page
Chapter Seven Review
Review of Slides
Review of Identifications
| Row | Structure | Abbreviation | Optimal Stain | Representative Section | Note |
|---|---|---|---|---|---|
| 1 | Endothelial Cell | EC | H&E | |
|
| 2 | Lacteal | L | H&E | |
|
| 3 | Lamina Propria | LP | H&E | |
|
| 4 | Villus | V | H&E | |
|
| 5 | Intestinal Gland (Crypt) | Gl | H&E | |
|
| 6 | Lymphatic Vessel | LV | H&E | |
|
| 7 | Lymphatic Tissue (Lamina Propria) | LP/LT | H&E | |
|
| 8 | Diffuse Lymphatic Tissue | (none) | H&E | |
|
| 9 | Peyer's Patches (Aggregated Lymphoid Nodules) | LN | H&E | |
|
| 10 | Submucosa | SubM | H&E | |
|
| 11 | Secondary Lymphoid Nodule | (none) | H&E | |
|
| 12 | Germinal Center | GC | H&E | |
|
| 13 | Corona | C | H&E | |
|
| 14 | B Lymphocyte Precursor | Bp | H&E | |
|
| 15 | Mitotic Figures | MF | H&E | |
|
| 16 | Differentiated Lymphocyte | DL | H&E | |
|
| 17 | Primary Nodule | (none) | H&E | |
|
| 18 | Secondary Nodule | (none) | H&E | |
|
| 19 | Epithelium | Ep | H&E | |
|
| 20 | Tonsillar Crypt | TC | H&E | |
|
| 21 | Lymphatic Nodule | LN | H&E | |
|
| 22 | Stratified Squamous Epithelium | SSE | H&E | |
|
| 23 | Trabecula of Tonsil | (none) | H&E | |
|
| 24 | Capsule | C | H&E | |
|
| 25 | Superficial Cortex | SC | H&E | |
|
| 26 | Deep Cortex | DC | H&E | |
|
| 27 | Medulla | M | H&E | |
|
| 28 | Hilus of Lymph Node | (none) | H&E | |
|
| 29 | Subcapsular (Cortical) Sinus | CS | H&E | |
|
| 30 | Lymph Node | LN | H&E | |
|
| 31 | Trabecular Sinus | TS | Reticulin | |
|
| 32 | Capillary | C | H&E | |
|
| 33 | Medullary Sinus | MS | H&S | |
|
| 34 | Medullary Cords (of Lymphocytes) | MC | H&E | |
|
| 35 | Reticular Cell | RC | H&E | |
|
| 36 | Macrophage | M | H&E | |
|
| 37 | High Endothelial (Post-capillary) Venule | (asterisk), (arrows) | H&E | |
|
| 38 | Hilus of Spleen | (none) | Aniline Blue | |
|
| 39 | Mesothelium | (none) | Aniline Blue | |
|
| 40 | Artery | (none) | Aniline Blue | |
|
| 41 | Trabecula of Spleen | T | Aniline Blue, Reticulin | |
|
| 42 | Venous Sinus | VS | Aniline Blue, Reticulin | |
|
| 43 | White Pulp | WP | Aniline Blue | |
|
| 44 | Red Pulp | RP | Aniline Blue | |
|
| 45 | Central Artery | CA | Aniline Blue | |
|
| 46 | Vein | (none) | Aniline Blue | |
|
| 47 | Artery | (none) | Aniline Blue | |
|
| 48 | Trabecular Vein | TV | Reticulin | |
|
| 49 | Capsule | (none) | H&E | |
|
| 50 | Endothelial Cell Nucleus | N | Aniline Blue | |
|
| 51 | Basement Membrane | BM | Aniline Blue | |
|
| 52 | Reticular Cells of Spleen | RC | Reticulin | |
|
| 53 | Trabeculae of Thymus | T | H&E | |
|
| 54 | Medulla of Thymus | M | H&E | |
|
| 55 | Cortex of Thymus | C | H&E | |
|
| 56 | Hassall's Corpuscle | H | H&E | |
|
| 57 | Epithelioreticular Cells | E | H&E | |
Top of page
Comments
Top of page -- AshleyLPistorio - 27 May 2007Edit | Attach | Print version | History: r2 < r1 | Backlinks | View wiki text | More topic actions
Topic revision: r2 - 20 Jun 2015, LorenEvey
- Epithelium
- Connective Tissue
- Muscle
- Nervous Tissue
- Cardiovascular System
- Skin Appendages and Sensory Receptors
- Lymphatic System
- Cartilage and Bone
- Respiratory System
- Peripheral Blood and Bone Marrow
- Oral Cavity and Salivary Glands
- Esophagus and Gastrointestinal Tract
- Pancreas, Liver, and Gall Bladder
- Endocrine Organs
- Male Reproductive System
- Female Reproductive System
- Urinary System
 Copyright © by the contributing authors. All material on this collaboration platform is the property of the contributing authors.
Copyright © by the contributing authors. All material on this collaboration platform is the property of the contributing authors. Ideas, requests, problems regarding Medical Histology? Send feedback